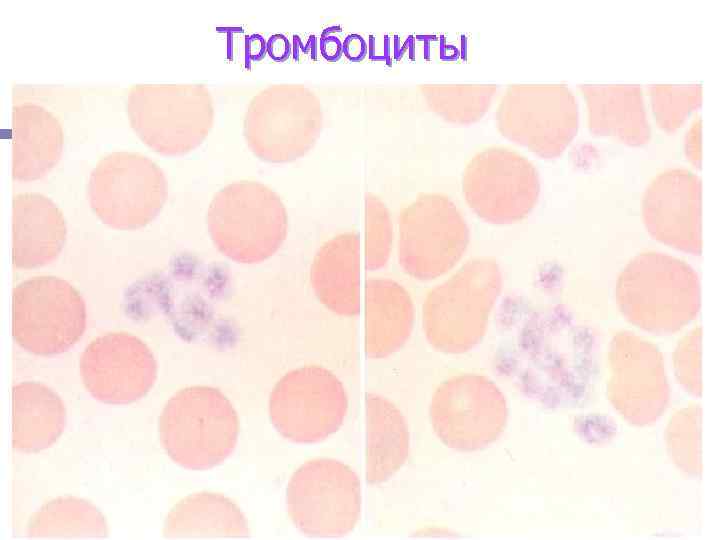

Гемоцитопоэз и его регуляция.ppt
- Количество слайдов: 110

ФИЗИОЛОГИЯ КРОВИ ГЕМОЦИТОПОЭЗ И ЕГО РЕГУЛЯЦИЯ проф. Кубарко А. И.







Кто в организме выполняет «дозорную» функцию и считает число форменных элементов ? ? ?

Рембрандт Харменс ван Рейн «Ночной дозор» 1642 г



Эмбриональные (тотипотентные) стволовые клетки (слева), гемопоэтические полипотентные стволовые клетки (справа)


Локальные условия нормального гемопоэза: -размещение СКК среди клеток микроокружения костного мозга (фибробласты, ретикулярные клетки, адипоциты, эндотелий, макрофаги); - действие на рецепторы СКК локальных сигнальных молекул микроокружения (стимулирующих деление – ИЛ-1, 3, 4, 6, 7; ФСК; ГКСФ, МГ-КСФ, М-КСФ, ЛИФ; ингибирующих – ФНО- α, трансформирующих ростовых факторов β 1 , β 2 ; - фиксация СКК в матриксе ( молекулами внеклеточного матрикса : коллаген, фибронектин, ламинин, глюкозаминогликаны, молекулы адгезии – интегрины, L-селектины, ICAM и др. ) - наличие источников железа для эритроцитов (макрофаги) и других веществ, необходимых для образования клеток

Возможные варианты дифференцировки гемопоэтических стволовых клеток костного мозга

Лечение инфаркта миокарда локальным введением стволовых гемопоэтических клеток и стимуляторов их дифференцировки (Г-КСФ)

Регенерация миокарда после введения гемопоэтических стволовых клеток в очаг некроза

Cхема кроветворения и миграции клеток крови


Наибольшим пролиферативным потенциалом обладает СКК – из нее образуются миллионы миелиодных и лимфоидных полиолигопотентных стволовых клеток; С каждым последующим шагом дифференцировки пролиферативный потенциал клеток уменьшается и предшественники зрелых клеток крови (например, проэритробласт) могут делиться только 1 раз; С каждым последующим шагом дифференцировки клетки приобретают специфические рецепторы, обеспечивающие повышение их чувствительности к новым сигнальным молекулам, направляющим их дифференцировку в определенный ряд кроветворных клеток и “обучающим” их выполнять специфические функции



Клеточный цикл состоит из двух периодов: • • клеточного роста, называемого «интерфаза» , во время которого идет синтез ДНК, белков, липидов и осуществляется подготовка к делению клетки. клеточного деления, называемого «фаза М» (от слова mitosis — митоз). Интерфаза состоит из G 1 -фазы · S-фазы · G 2 -фазы • • • G 1 -фаза (от англ. gap — промежуток) - синтеза м. РНК, белков, других клеточных компонентов; S-фаза (от англ. synthesis — синтетическая) – репликации ДНК клеточного ядра G 2 -фаза, во время которой идет подготовка к митозу

Регуляция клеточного цикла Осуществляется цитокинами и факторами роста через стимуляцию их рецепторов и экспресcию генов, контролирующих синтез циклинов и циклин-зависимых киназ (ЦЗК). ИЛ-3, Г-КСФ активируют синтез ЦЗК и образование комплексов «ЦЗК -циклин» , необходимых для перехода СКК из фазы G 1 в фазу S; Ингибиторы гемопоэза тормозят синтез ЦЗК и переход СКК из фазы G 1 в фазу S




Эритроциты Регуляция эритропоэза







Модель эритропоэза







Зрелые эритроциты (слева) и их предшественники - ретикулоциты (справа) 0. 5 – 1. 2%






















Механизмы остановки и миграции нейтрофилов и других лейкоцитов в ткани - в условиях нормы лейкоциты перемещаются вдоль поверхности эндотелия не прилипая к ней; - перемещение, прилипание и миграция лейкоцитов контролируются хемокинами и адгезионными молекулами поврежденного эндотелия или активированного молекулами ИЛ-1, ФНО; - адгезионные молекулы взаимодействуют с комплементарными адгезионными и рецепторными молекулами лейкоцитов - тип хемокинов и адгезионных молекул, образуемых активированным эндотелием, зависит от их «сцепляемости» с различными видами лейкоцитов















Лимфопоэтическая система включает Т и В лимфоциты циркулирующей крови, лимфоидные органы (лимфатические узлы, селезенка, тимус, лимфоидная ткань слизитых оболочек ротоглотки, бронхов, кишечника) n Выделяют: n В-лимфоциты (1015%) Т-лимфоциты (60 - n 80%) - киллеры, хелперы, эффекторы, супрессоры n n ЕК - естественные киллеры (нуль клетки) другие формы




Структура В -лимфоцитов: А -в покое; Б- при активации







Рецепторные механизмы влияния эритропоэтина (ЭПО) на эритропоэз





Рецепторы и лиганды гемопоэтических клеток






Модель эритропоэза

Пути миграции клеток крови в организме


Структура молекулы гемоглобина
Тромбоциты




Фаза G 1 -клетка в диплоидном состоянии; фаза S – синтез ДНК; фаза G 2 репликация ДНК и переход в тетраплоидное состояние; М - митоз

Гемоцитопоэз и его регуляция.ppt